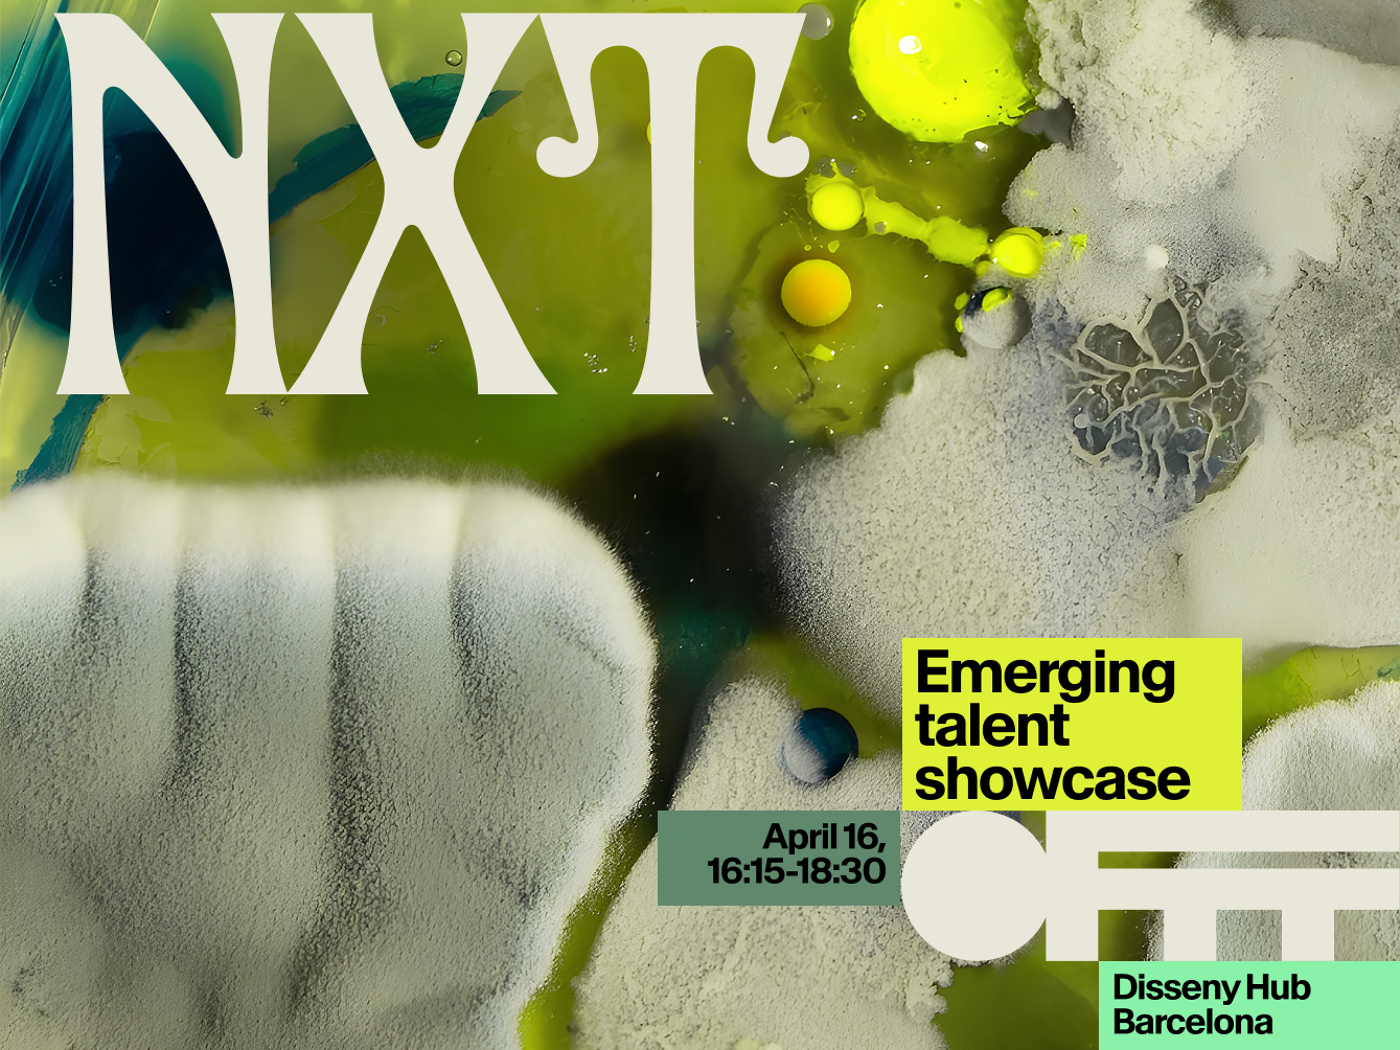
This poster advertises an event called NXT, an emerging talent showcase happening on April 16th from 16:15 to 18:30 at Disseny Hub Barcelona.

Eventos
Tres estudiantes del Grado en Diseño Gráfico presentan su proyecto "Mobio" en OFFF Barcelona 2026
Jaume Álvarez, Olivia Duffin e Iris García representan a LCI Barcelona en la sección NXT de OFFF, el festival internacional de diseño y creatividad que celebra su nueva edición estos días en el Disseny Hub.